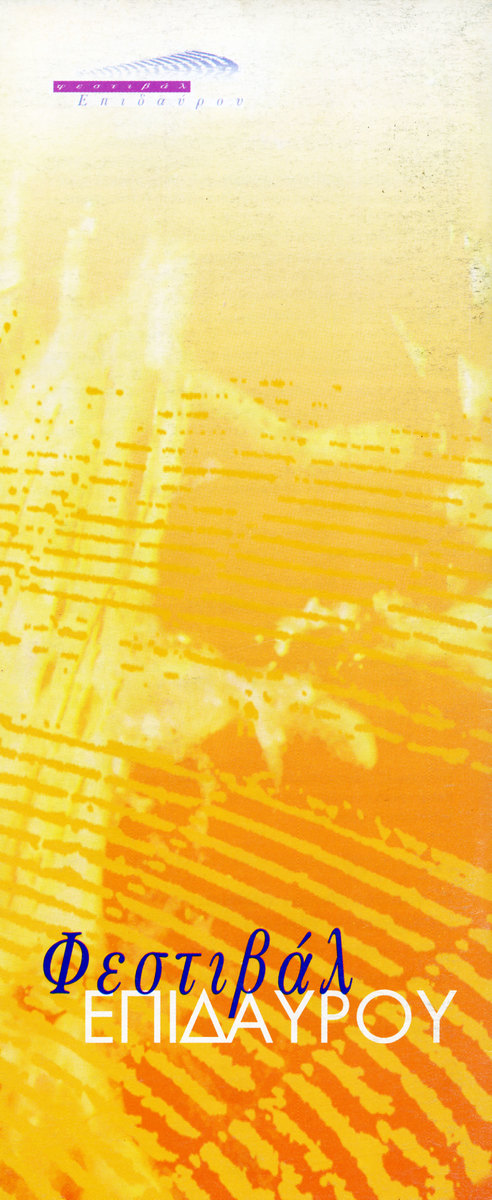
Thumbnail

Κρατική Ορχήστρα Αθηνών
Χορωδία της Ε.Ρ.Τ.
Χορωδία Μακεδονίας
Συναυλία της Κρατικής Ορχήστρας Αθηνών – Έργα Θεοδωράκη
1999
| ΕΙΔΟΣ | Μουσική |
|---|---|
| ΕΤΟΣ | 1999 |
| ΗΜΕΡΟΜΗΝΙΕΣ ΠΑΡΑΣΤΑΣΕΩΝ |
10.07.1999 |
| ΧΩΡΟΣ |
Ωδείο Ηρώδου Αττικού Αθήνα |
|
Θεοδωράκης, Μίκης [“Κατά Σαδδουκαίων” καντάτα σε 7 μέρη (ποίηση: Κατσαρός, Μιχάλης), “Αμήν (Μετά των Αγίων)” από το Requiem “Ἀκολουθία εἰς κεκοιμημένους”] |
|
| ΣΥΝΤΕΛΕΣΤΕΣ |
Μουσική διεύθυνση: Καρυτινός, Λουκάς [Κατά Σαδδουκαίων] / Θεοδωράκης, Μίκης [Αμήν (Μετά των Αγίων)] |
| ΕΡΜΗΝΕΥΤΕΣ / ΕΡΜΗΝΕΥΤΡΙΕΣ |
Σολίστ: Τερζάκης, Ζάχος [οξύφωνος] |
| ΠΑΡΑΤΗΡΗΣΕΙΣ |
Η ερμηνεία ήταν αφιερωμένη στην μνήμη του Μιχάλη Κατσαρού. |